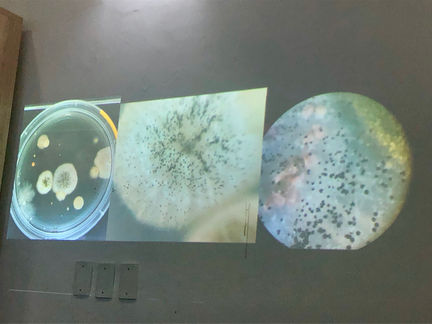

ConversAções
#Plantar Artes Colher Cidades
junho/2019
Plantar artes | Colher cidades foi um ConversAções realizado em processo, com uma programação de atividades em três momentos, abrangendo diferentes abordagens às artes, às ciências e à experimentação, e à relação natureza e cidade.
No sábado de manhã, 11/05/2019, João Miguel Lima e Salvia Braga
participaram da Feira Agroecológica do Benfica, na Praça da Gentilândia, com uma banquinha de vasos de planta para troca ou venda, entre suculentas, cactos e beldroegas (estas, plantas ocupadeiras, colhidas das ruas e hospedadas em vasos). E seguiu-se uma sessão de bordado livre em folhas secas, que atraiu a participação de adultos e crianças
para o chão da praça, experimentando com o bordado em folhas secas colhidas pela cidade.
Em 4 de junho, o encontro contou com Fabíola Fonseca, Salvia Braga e João Miguel Lima na Livraria Lamarca, Benfica. Fabíola apresentou experimentações de bioarte em laboratório, potencializadas com a fotografia e a performance, como os trabalhos Protocolo Fungo (para conhecer mais, clique aqui), dedicado aos seresmicroscópicos na interface com tecnologia, vigilância e cidade, e o Manual de como fazer sua mosca transgênica, sobre o qual ela escreveu:
Produzimos moscas (supostamente) transgênicas para fazer essa composição entre ciência e arte. Do laboratório à galeria. Pensar nessas moscas é atritar as fronteiras que separam ciência e arte. É aproximar, é compor. É produzir outra ciência e outra arte. Esse encontro desmonta aquilo que está estabelecido e cria outras possibilidades de habitar mundos [Trecho do encarte distribuído na exposição Moscas transgênicas, em cartaz na Azougue Galeria, em Fortaleza, no mês de setembro de 2019].
Da pesquisa sobre as ocupadeiras, plantas que nascem das fissuras de
construções e calçadas, João Miguel partilhou narrativas e encontros suscitados a partir de fotografias da planta chanana e suas flores. Embora nativa, medicinal e de flor, a planta costuma ser removida de canteiros, praças e calçadas, devido à impressão generalizada de que se trata de “mato”. Com histórias sobre remédios caseiros e jardinagem de guerrilha, João Miguel lançou a zine Chananas – itinerários urbanos colaborativos.
Salvia apresentou questões sobre fazer casa, ocupar e resistir que perpassaram sua pesquisa no mestrado em Artes quanto aos usos da chamada “Casa do
Barão de Camocim”, no bairro Centro, onde realizou, entre outras intervenções, o
plantio de uma espiral de ervas no jardim externo (obra Replantio). Apresentou também outros desdobramentos, como a obra Casa (Im)própria, exposta em 2018 no Museu de Arte da UFC, com fotografias de casas onde morou na infância e fotos atuais delas, demolidas. A sua dissertação, intitulada Intervenções com a Casa: do Barão, da Vila, das
Artes, da Cidade, foi orientada por Deisimer Gorczevski e defendida no início de 2019.
O terceiro momento deste ConversAções aconteceu em 16/06/2019, em movimento
de caminhada pela Praça Luíza Távora, bairro Aldeota. Larissa Batalha contou de sua pesquisa sobre as plantas alimentícias não convencionais (PANCs), identificando algumas dessas espécies naquele local e como havia sido esse levantamento. Ela também lançou questões sobre o uso e a ocupação de espaços urbanos na perspectiva da segurança alimentar e lazer, em contextos de desigualdade e crise, e falou também de suas experimentações artísticas recentes, dedicadas a ilustrar pássaros, reais e inventados.
O convidado Jared Domício apresentou inquietações em torno de uma sociedade vegetal, colocada em analogia à sociedade humana – questões que antecediam o projeto artístico Vegetocracia e a exuberância dos dias comuns e perpassavam outras obras e projetos seus em residências artísticas. Na sua pesquisa, Jared mergulhou também no desafio de articular arte e ciência com saberes antigos, como a literatura hermética e saberes rurais.